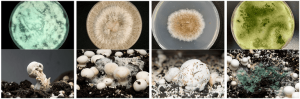

انواع بیماریهای قارچ دکمهای و راهکارهای پیشگیری و درمان
قارچ دکمهای یکی از پرمصرفترین و پرطرفدارترین قارچهای خوراکی در ایران و جهان است؛ اما پرورش آن مستلزم مراقبت دقیق از نظر بهداشتی و فنی است، چراکه بیماریهای قارچی و باکتریایی میتوانند عملکرد مزرعه را بسیار کم کنند و باعث افت شدید در کیفیت و قیمت شوند. در این مقاله جامع و سئوشده از قارچ برتر، تولیدکننده قارچ خوراکی و فروشنده کمپوست و خاک پوششی، به بررسی کامل بیماریهای قارچ دکمهای – از جمله کپک خاکستری، کپک سفید، پوسیدگی قهوهای، لکه سیاه، کپک سبز و لکه باکتریایی – و راهکارهای پیشگیری و درمان آنها میپردازیم. با این راهنما، میتوانید یک پرورش سالم، پربازده و باکیفیت داشته باشید.
فهرست مطالب
- مقدمه
- اهمیت شناخت بیماریهای قارچ دکمهای
- انواع بیماریها
- علائم تشخیصی هر بیماری
- روشهای پیشگیری
- راهکارهای درمان
- سوالات متداول (FAQ)
- معرفی برند قارچ برتر
- نتیجهگیری
1. مقدمه
پرورش قارچ دکمهای به دلیل ارزش غذایی بالا و تقاضای بازار، جذاب و پرسود است؛ اما بدون توجه به مسائل بهداشتی، این صنعت میتواند به سرعت دچار بحران شود…
2. اهمیت شناخت بیماریهای قارچ دکمهای
بیماریهای قارچی و باکتریایی باعث کاهش حجم محصول، افت کیفیت ظاهری، کاهش قیمت فروش و در برخی موارد مصرفکنندگان را دچار مشکلات گوارشی میکنند…
3. انواع بیماریهای قارچ دکمهای
3.1 کپک خاکستری (Botrytis cinerea)
علائم: رشد خاکستری روی کلاهک قارچ؛ قارچها نرم، مرطوب و لهشده هستند.
پیشگیری/درمان: تهویه مناسب، تمیزی سالن، استفاده محدود از قارچکشها
3.2 کپک سفید (Sclerotinia sclerotiorum)
علائم: پوشش پنبهای سفید روی قارچ و بستر…
3.3 پوسیدگی قهوهای (Mycogone perniciosa)
علائم: لکههای قهوهای روی کلاهک؛ تودههای پنبهای سفید…
3.4 لکه سیاه (Black Spot)
علائم: لکههای سیاه روی کلاهک؛ ظاهر کثیف و پژمرده…
3.5 کپک سبز (Trichoderma spp.)
علائم: کپک سبز رنگ روی بستر و قارچها؛ کاهش رشد میسیلیوم…
3.6 لکه باکتریایی (Pseudomonas tolaasii)
علائم: لکههای زرد تا قهوهای روی کلاهک؛ قارچ نرم و مرطوب…
4. علائم تشخیصی بیماریها
| نوع بیماری | علائم ظاهری و تشخیصی |
|---|---|
| کپک خاکستری | پوشش خاکستری روی کلاهک، قارچ نرم و لهشده |
| کپک سفید | پوشش پنبهای سفید روی سطح قارچ یا بستر |
| پوسیدگی قهوهای | لکههای قهوهای، بوی بد و رشد غیرطبیعی میسیلیوم |
| لکه سیاه | لکههای سیاه روی کلاهک، کاهش زیبایی ظاهری قارچ |
| کپک سبز | ظاهر شدن کپک سبز روی بستر و قارچها، کاهش رشد میسیلیوم |
| لکه باکتریایی | لکههای زرد تا قهوهای روی کلاهک، بافت نرم و مرطوب در ناحیه لکهدار |
5. روشهای پیشگیری
- کنترل رطوبت ۸۵–۹۰٪ و دمای ۱۸–۲۳ درجه
- تهویه منظم برای کنترل CO₂ و رطوبت
- ضدعفونی مرتب سالن و ابزار
- استفاده از کمپوست و خاک پوششی بهداشتی
- حذف قارچهای بیمار

6. راهکارهای درمان
- استفاده از قارچکشهای مجاز
- ضدعفونی با محلولهای مخصوص
- جداسازی سریع قارچهای آلوده
برای مشاهده و سفارش خرید قارچ دکمهای، یا مطالعه در مورد کود ورمی کمپوست، به فروشگاه قارچ برتر سر بزنید.
7. سوالات متداول (FAQ)
۱. چطور کپک خاکستری را سریع تشخیص بدهم؟
کپک خاکستری با ایجاد پوشش خاکستری رنگ و مرطوب روی سطح کلاهک قارچ ظاهر میشود. بافت قارچ در این حالت نرم، خیس و لهشده است. این بیماری اغلب در شرایط رطوبت بالا و تهویه ضعیف گسترش مییابد.
۲. تفاوت کپک سفید و کپک خاکستری چیست؟
کپک سفید معمولاً به صورت پوشش پنبهای سفید روی بستر یا ساقه قارچ ظاهر میشود و ممکن است با میسیلیوم اشتباه گرفته شود، در حالی که کپک خاکستری سطح کلاهک را درگیر میکند و بافت قارچ را خراب میکند.
۳. آیا خاک پوششی نقش زیادی در جلوگیری از بیماریها دارد؟
بله، خاک پوششی اگر آلوده باشد، میتواند منبع ورود بسیاری از عوامل بیماریزا به مزرعه باشد. استفاده از خاک پوششی تمیز و استریل شده، تأثیر زیادی در جلوگیری از رشد کپکها و باکتریها دارد.
۴. تهویه سالن پرورش چقدر اهمیت دارد؟
هوا یکی از اصلیترین عوامل در کنترل دما، رطوبت و گاز CO₂ در سالن پرورش است. تهویه نامناسب زمینهساز رشد قارچهای بیماریزا و ایجاد کپک خواهد بود.
۵. برای ضدعفونی سالن از چه موادی استفاده کنم؟
از محلول فرمالین ۲٪، آهک زنده یا محلولهای ضدعفونیکننده مخصوص کشاورزی استفاده کنید. بهتر است قبل از ورود کمپوست، سالن کاملاً ضدعفونی و خشک شود.
۶. آیا کمپوست هم میتواند عامل بیماری باشد؟
اگر کمپوست از منابع غیرمطمئن و در شرایط غیربهداشتی تهیه شده باشد یا پاستوریزاسیون ناقص داشته باشد، میتواند ناقل کپکها و باکتریها باشد. استفاده از کمپوست استریلشده و بهداشتی بسیار مهم است.
7. چه زمانی باید قارچهای آلوده را حذف کرد؟
به محض مشاهده علائم بیماری (لکه، کپک، تغییر رنگ یا نرمشدگی)، باید قارچ آلوده را سریعاً از بستر جدا کرده و محل آلودگی ضدعفونی شود تا از گسترش بیماری جلوگیری شود.
8. آیا میتوان بیماریها را بهطور کامل ریشهکن کرد؟
خیر، اما میتوان با رعایت بهداشت، تهویه صحیح، مواد اولیه سالم و واکنش سریع به آلودگیها، احتمال بروز بیماری را تا حد زیادی (بیش از ۹۵٪) کاهش داد.
9. در صورت شیوع بیماری، چه کاری باید انجام داد؟
ابتدا قارچهای آلوده را حذف کنید، محل آلوده را با مواد مناسب ضدعفونی کرده و شرایط محیطی مانند دما، رطوبت و تهویه را اصلاح نمایید. در موارد جدی، استفاده از قارچکشهای مجاز با مشورت کارشناس فنی ضروری است.
8. معرفی برند قارچ برتر
قارچ برتر با تجربه چندین ساله در تولید قارچ دکمهای و تامین کمپوست و خاک پوششی استریل، همواره در تلاش است تا کیفیت و سلامت را در مزرعه شما تضمین کند. انتخاب محصولات قارچ برتر یعنی تضمین درصد بازدهی و سلامت خوراکتان.
9. نتیجهگیری
شناخت کامل انواع بیماریهای قارچ دکمهای و اقدامات پیشگیرانه و درمانی دقیق سبب میشود تا بالاترین بازده و کیفیت حاصل شود. استفاده از کمپوست و خاک پوششی استاندارد، رعایت بهداشت، کنترل شرایط محیطی و حذف بهموقع قارچهای آلوده، راز موفقیت شماست. برای تهیه محصولاتی که مسیر رشد شما را هموارتر میکند، فقط کافیست سری به فروشگاه قارچ برتر بزنید.
قارچ برتر با ارائه کمپوست، خاک پوششی، مشاوره و آموزش تولید و پرورش قارچ خوراکی، در کنار شماست تا یک کسبوکار موفق در زمینه پرورش قارچ داشته باشید.
واحد فروش و امور مشتریان:
۰۲۱۵۶۵۴۵۹۰۴
۰۹۱۲۷۰۲۱۸۲۸



بدون دیدگاه